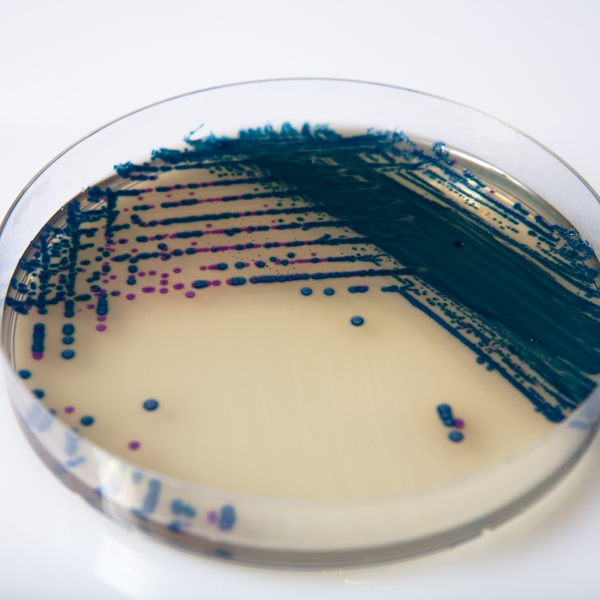
CHROMagar™ StrepB

Colonies Appearance

Group B Streptococcus
Mauve

Other Microorganism
Blue, colourless or inhibited
Performance
Performance
GBS in pregnant women: The Group B Streptococci (GBS), also known under the name of Streptococcus agalactiae, are the cause of numerous infections in adults but mostly an important cause of serious neonatal infections, occuring in the three first weeks of life. Studies indicate that approximately 12-27 % of pregnant women are colonised by GBS. (WHO, Infectious diseases, Group B Streptococcus). Detecting vaginal (and in some countries also rectal) colonisation by GBS in pregnant women is the most effective strategy to prevent infection transmission during baby delivery.
Worldwide, official guidelines recommend prenatal screening of GBS in the last month of pregnancy. In GBS-carrying women, this screening allows determining the need of intrapartum antibiotic prophylaxy, which has been proved effective in preventing the infections occuring in the first week of life (known as early-onset GBS infections).
Intended Use :
CHROMagar™ StrepB is a selective chromogenic culture medium that is intended to aid in the qualitative determination of Group B Streptococcus (GBS) colonization in pregnant women. This medium supports the growth of hemolytic and non-hemolytic GBS strains. The test is performed by direct, or after enrichment, plating of urine, vaginal and/or vagino/rectal swabs obtained from pregnant women. CHROMagar™ StrepB results can be interpreted after 18-24 h aerobic incubation at 35-37 °C.
CHROMagar™ StrepB is not intended to diagnose infection nor to guide nor monitor treatment for infections. Further identification, susceptibility testing and epidemiological typing is needed on suspect colonies.
1. Easy Interprétation : Easier reading thanks to an intense mauve colony colouration.
3. High specificity : Differentiation of GBS from other bacteria by selective inhibition or by counter-colouration.
 <img src="https://media.loveitopcdn.com/42030/Data-EN-5-1756443576.png" width="1024" height="515" alt="" title="Data EN" />
<img src="https://media.loveitopcdn.com/42030/Data-EN-5-1756443576.png" width="1024" height="515" alt="" title="Data EN" /> Composition
 <img class="vce-single-image" src="https://media.loveitopcdn.com/42030/Composition-EN-1-1756443578.png" width="720" height="480" alt="" title="Composition EN" />
<img class="vce-single-image" src="https://media.loveitopcdn.com/42030/Composition-EN-1-1756443578.png" width="720" height="480" alt="" title="Composition EN" /> Technical Documents
Scientific Publications
2023
Utilidad del CHROMagarTMStrepBpara la detección de Streptococcus agalactiaeen hisopado vaginorrectalde gestantes
📄 Publication2023
Group B Streptococci Colonization in Pregnant Guatemalan Women: Prevalence, Risk Factors, and Vaginal Microbiome
📄 Publication2023
Fluctuation of Group B Streptococcus colonization rates in pregnant women according to COVID-19 pandemic-related events in Brazil
📄 Publication2022
Group B Streptococcus colonization among pregnant women before and after the onset of the COVID-19 pandemic in Brazil
📄 Publication2019
Identification of Group B Streptococcus on Chromogenic Medium CHROMagar StrepB by MALDI-ToF Mass Spectrometry
📄 Publication2016
Evaluation of conventional and CHROMagar methods for the detection of Group B Streptococcus in antenatal cases
📄 Publication2015
Group B Streptococcus (GBS). Bacteruria in Prengancy. Comparison of four culture media
📄 Publication2015
Evaluation of four chromogenic media for the isolation of Group B Streptococcus from vaginal specimens in pregnant women
📄 Publication2014
CHROMagar Strep B and Granada Media for detection of group B Streptococcus in vaginal/rectal prenatal screening
📄 Publication2014
Comparison of culture-based methods for Group B Streptococcus detection in screening samples from pregnant women
📄 Publication2013
Evaluation of Trans-Vag Broth, Colistin-Nalidixic Agar and CHROMagar StrepB for Detection of Group B Streptococcus in Vaginal and Rectal Swabs from Pregnant Women in South Africa
📄 Publication2012
Comparison of CHROMagar StrepB, Columbia CNA agar and Lim broth for the isolation of Group B Streptococcus from vaginal and rectal swabs from South Africa
📄 Publication2012
Prepartum vaginal/anorectal Group B Streptococcus screening: Improvement of the enrichment step by the broth additive RambaQUICK StrepB
📄 Publication2011
Evaluation of CHROMagar™ StrepB agar, an aerobic chromogenic medium for prepartum vaginal/rectal Group B Streptococcus screening
📄 Publication2010
Détection rapide par culture de Streptococcus agalactiae dans les prélevements génitaux sur un nouveau milieu chromogène: CHROMagar StrepB
📄 Publication2010
Rapid Detection with culture media of Streptococcus agalactiae in genital samples on a new chromogenic media CHROMagar StrepB
📄 Publication2010
Comparison of the Rate of Recovery of Group B Streptococci from Genital Specimens Inoculated into Group B Selective Broth and Sub-cultured to Neomycin Nalidixic Acid Plates and Three Different Chromogenic Media
📄 Publication2010
Group B Streptococcus Detection by Carrot Broth/CHROMagar Colorex GBS Agar vs. Conventional Colistin/Nalidixic Acid Agar/Group B Strep Broth Method
📄 Publication2010
Evaluation of CHROMagar™ StrepB: A new chromogenic agar medium for aerobic detection of Group B Streptococci in perinatal samples
📄 Publication2010
Perpartum anti Group B Streptococcus Antibioprophylaxis : What would be the impact of the CDC’s Guidelines in a French Hospital ?
📄 Publication2010
Perpartum antibioprophylaxis : comparison of Group B Streptococcus detection rates of two chromogenic media and blood agar for its isolation in pregnant women vaginal swabs
📄 Publication

Read more